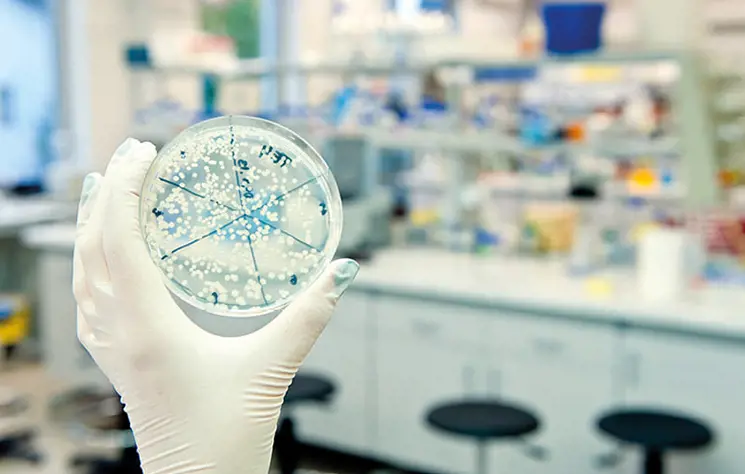

Around 50 – 60 people from across the UK attended the Uveal Melanoma Patients Symposium as part of the UMCure 2020 project annual update, at the North West Cancer Research Centre at the University of Liverpool.
UMCure 2020 is Research Consortium of 12 of Europe’s most influential uveal melanoma experts, researchers and clinicians.
Funded by the European Union’s Horizon 2020 programme, the five-year programme grant totalling €6M, which started in 2016, aims to identify and validate new therapies for the treatment of metastatic uveal melanoma.
Around 800 people in the UK are diagnosed each year with uveal melanoma, and 300 of these cases are referred to the centre of excellence based at the Royal Liverpool University Hospital.
The Ocular Oncology Centre at the Royal works closely with Aintree University Hospital and Clatterbridge Cancer Centre, to provide UM patients with state-of-the-art treatment for both the eye tumour and disseminated disease.
When limited to the eye, UM treatment is very successful, using plaque radiotherapy, proton beam therapy and in some cases surgery – with the most patients retaining their sight as a result of these effective treatments.
In around 50% of UM patients, however, secondary tumours develop when the UM spreads to the liver. At present, there is no effective treatment for metastatic UM. The aims of the UMCure 2020 research is to better understand the biology of these secondary tumours in the liver, and discover effective ways to treating them.
Professor Sarah Coupland, Director of the North West Cancer Research Centre at the University of Liverpool, said: “Rare cancers such as uveal melanoma have historically not benefitted from extensive research as some of the more commonly occurring cancers.
“The UMCure 2020 Research Consortium has been developed to ensure we invest in effective research in the search for new treatment strategies and options for UM patients with disseminated disease.
“We have a big job ahead of us, but by combining the knowledge and resources of clinicians and researchers from all over Europe we are making significant head way into our understanding of this cancer, why it occurs and how we might treat it.”
The UMCure 2020 conference will took place November 30th and December 1st at the North West Cancer Research Centre at the University of Liverpool. The Centre recently benefitted from a £1million funding grant from charity, North West Cancer Research, which will sustain the Centre through to 2021.
During the two-day conference, patients will have the opportunity to speak to researchers and clinicians who are at the forefront of cancer research and treatment, as well as have a chance to shape research outcomes by sharing their own personal treatment journey.
Melanoma Patient Network Europe, the pan-European patient group who are a partner in the Horizon 2020 project, are even helping direct research itself with expert patients sat on the Scientific Advisory Board.
Iain Galloway, who has been liaising with the Research Consortium since its inception and is a patient advocate, has been diagnosed with both UM and secondary cancer to the liver and is just one of the patients who will attend.
The 50-year-old was told he had UM nine years ago after his optician noticed a lump on the inside of his eye. After undergoing treatment for UM, which eventually included the removal of his left eye, he was told he had developed metastatic cancer to the liver.
He had a last-chance operation to remove 13 tumours and 70% of his liver, and since 2014 several subsequent treatments including immunotherapy and two additional liver surgeries. Overall survival in those who have the disease spread is less than 10%
Iain said: “My cancer experience has been a long and eventful one and I know all too well the devastation a cancer diagnosis can bring. We know it will come back again.
“Having combined my day job with patient advocacy for three years and working with a range of patient groups, research institutions and health organisations all over Europe, it’s great to see events like these which involve patients and make them integral to the work being done to invest in better treatments for them – treatments which could have an impact on their survival.
“Liverpool is one of the foremost treatment centres for both primary UM and secondary metastatic disease, and their continued focus on research into novel treatments for our disease must be applauded.”
More information on the UM Cure Project 2020 can be found: https://www.umcure2020.org/en/ and https://www.loorg.org